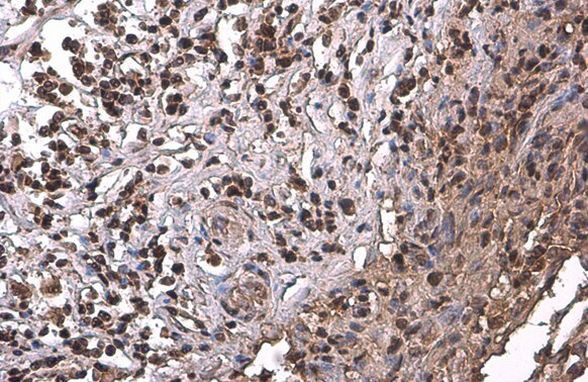
PRMT1 Antibody in Immunohistochemistry (Paraffin) (IHC (P))

Search
Invitrogen
PRMT1 Monoclonal Antibody (GT10111)
{{$productOrderCtrl.translations['antibody.pdp.commerceCard.promotion.promotions']}}
{{$productOrderCtrl.translations['antibody.pdp.commerceCard.promotion.viewpromo']}}
{{$productOrderCtrl.translations['antibody.pdp.commerceCard.promotion.promocode']}}: {{promo.promoCode}} {{promo.promoTitle}} {{promo.promoDescription}}. {{$productOrderCtrl.translations['antibody.pdp.commerceCard.promotion.learnmore']}}
图: 1 / 5
PRMT1 Antibody (MA5-31503) in IHC (P)





Please note: We are reviewing Western blot images included in the antibody testing data in our catalog, including those provided by third parties. Unless expressly labeled or annotated as “raw-unedited”, Western blot images included in the antibody testing data in our catalog may have been edited, optimized or otherwise adjusted for presentation.
产品信息
MA5-31503
种属反应
宿主/亚型
分类
类型
克隆号
抗原
偶联物
形式
浓度
规格
纯化类型
保存液
内含物
保存条件
运输条件
RRID
产品详细信息
Keep as concentrated solution.
Predicted reactivity: Mouse (100%), Rat (100%), Xenopus laevis (100%), Bovine (100%).
Positive Control: 293T, A431, HeLa, HepG2, Neuro2A, GL261, NIH-3T3, Raw264.7, C2C12.
Store product as a concentrated solution. Centrifuge briefly prior to opening the vial.
靶标信息
PRMT1 is a member of the protein arginine N-methyltransferase (PRMT) family. Arginine methylation is an irreversible post translational modification which has been implicated in RNA processing and trafficking, receptor-mediated signaling, and transcription. At least three types of PRMT enzymes have been identified in mammalian cells. These enzymes have been shown to have essential regulatory functions by methylation of key proteins in several fundamental areas. These proteins include nuclear proteins, IL enhancer binding factor, nuclear factors, cell cycle proteins, signal transduction proteins, apoptosis proteins, and viral proteins. The mammalian PRMT family currently consists of 7 members that share two large domains of homology. Increased expression of PRMT1 may play a role in various types of cancer.
仅用于科研。不用于诊断过程。未经明确授权不得转售。
篇参考文献 (0)
生物信息学
蛋白别名: arginine N-methyltransferase 1; heterogeneous nuclear ribonucleoproteins methyltransferase-like 2; Histone-arginine N-methyltransferase PRMT1; Interferon receptor 1-bound protein 4; Protein arginine N-methyltransferase 1
基因别名: 6720434D09Rik; AW214366; HMT2; HRMT1L2; IR1B4; Mrmt1; PRMT1
UniProt ID: (Mouse) Q9JIF0
Entrez Gene ID: (Mouse) 15469